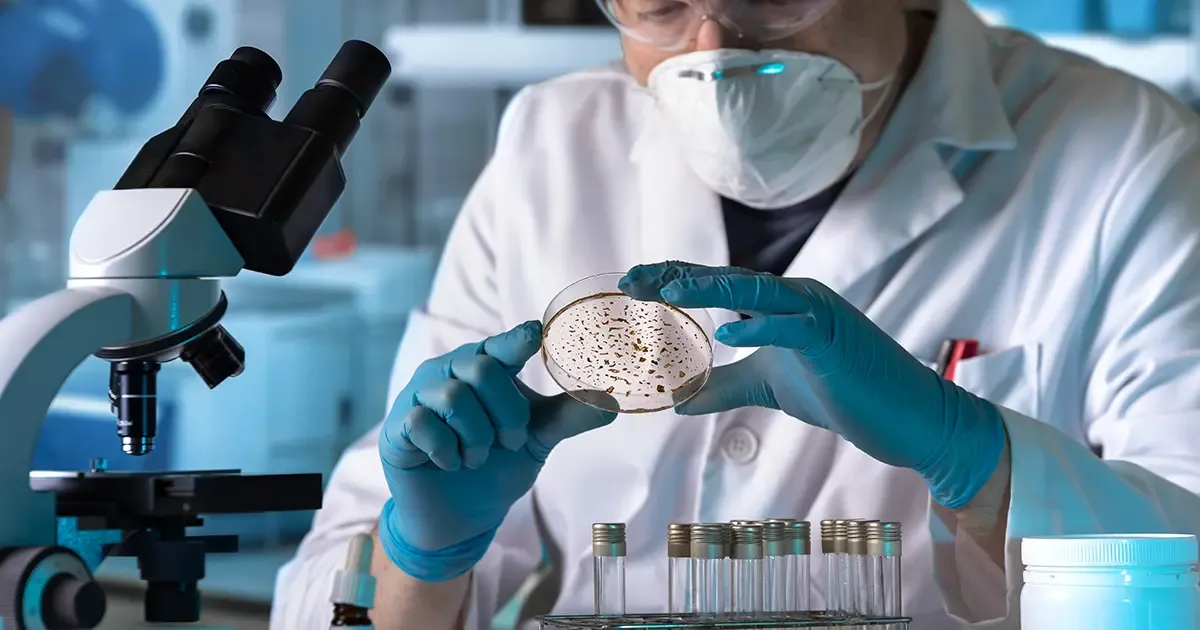
Medical Microbiology LIMS

Clinical Diagnostics LIMS
Manage patient samples and diagnostic workflows efficiently. Ensure rapid test processing with accurate data handling. Support patient privacy with secure systems in place. Integrate with hospitals and healthcare providers seamlessly. Improve diagnostic accuracy through automation tools.
Read more